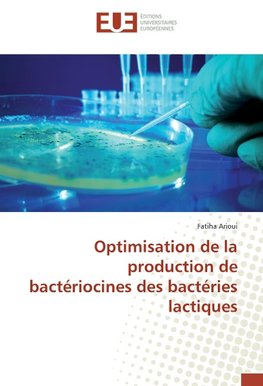
Optimisation de la production de bactériocines des bactéries lactiques

-
 Francúzsky jazyk
Francúzsky jazyk
Optimisation de la production de bactériocines des bactéries lactiques
Autor: Fatiha Arioui
L'activité inhibitrice de trois souches lactiques (Enterococcus faecalis BO2, Lactococcus lactis ssp lactis LV12 et Lactococcus lactis ssp diacetylactis LV4) est testé dans différents milieux de culture vis-à-vis Lactococcus sp H2.3. Le milieu MRS tamponné... Viac o knihe
Na objednávku, dodanie 2-4 týždne
64.41 €
bežná cena: 67.80 €
O knihe
L'activité inhibitrice de trois souches lactiques (Enterococcus faecalis BO2, Lactococcus lactis ssp lactis LV12 et Lactococcus lactis ssp diacetylactis LV4) est testé dans différents milieux de culture vis-à-vis Lactococcus sp H2.3. Le milieu MRS tamponné additionné de 25 % de lait écrémé semble être favorable à la production de bactériocines par les deux souches Enterococcus faecalis BO2 et Lactococcus lactis ssp lactis LV12, alors que le milieu M17 tamponné additionné de 25 % de lait écrémé est favorable à la production de bactériocine par la souche Lactococcus lactis ssp diacetylactis LV4. La cinétique de croissance et de production ont été étudiées pour ces deux milieux. La production de bactériocine est liée à la croissance. L'activité inhibitrice est maximale dans les milieux tamponné par du tampon phosphate de sodium à pH 6 et à pH 6,5, avec le glucose comme sucre. La température optimale de production de ces substances est de 30 °C.
- Vydavateľstvo: Éditions universitaires européennes
- Rok vydania: 2016
- Formát: Paperback
- Rozmer: 220 x 150 mm
- Jazyk: Francúzsky jazyk
- ISBN: 9783639508314

 Anglický jazyk
Anglický jazyk 










